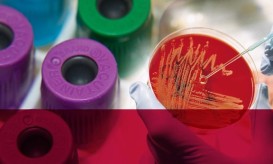

ΕΟΠΥΥ: “Πάρτι” πλαστών συνταγών και εις βάρος αναπήρων – Αναζητούνται ηλεκτρονικά ίχνη παντού
Οι έλεγχοι του ΕΟΠΥΥ για τις υπερσυνταγογραφήσεις και την προκλητή ζήτηση φαρμάκων και εξετάσεων, αναμένεται να επεκταθούν και στα...

Οι έλεγχοι του ΕΟΠΥΥ για τις υπερσυνταγογραφήσεις και την προκλητή ζήτηση φαρμάκων και εξετάσεων, αναμένεται να επεκταθούν και στα...

Σε πλήρες οικονομικό αδιέξοδο βρίσκονται οι προμηθευτές ιατροτεχνολογικών προϊόντων καθώς διογκώνονται συνεχώς τα χρόνια χρέη των νοσοκομείων του ΕΣΥ...

Από σήμερα σταματούν να τηρούν τους όρους της σύμβασης με τον ΕΟΠΥΥ για την παροχή ιατροτεχνολογικών προϊόντων στους ασφαλισμένους...

Επιστολή στον πρόεδρο του ΕΟΠΥΥ, Σωτήρη Μπερσίμη σχετικά με το "μπάχαλο", όπως το χαρακτηρίζουν, που έχει προκληθεί από τις...

Μιλώντας στο iatropedia την περασμένη εβδομάδα ο πρόεδρος του ΣΕΙΒ, Παύλος Αρναούτης, είχε προαναγγείλει ότι τα μέλη του Συνδέσμου...

Χωρίς ιατροτεχνολογικό εξοπλισμό λειτουργούν τα δημόσια νοσοκομεία καθώς ακόμα δεν έχει ανοίξει ο προϋπολογισμός του 2017 και οι διοικητές...

Παραπάνω από 3 ώρες διήρκεσε η χθεσινή συνάντηση των εκπροσώπων του ΠΦΣ με τον υπουργό Υγείας, Ανδρέα Ξανθό και...
Για τον έναν ή τον άλλο λόγο, οι προμηθευτές των δημόσιων νοσοκομείων έχουν δει τα ταμεία τους να αδειάζουν...

"Δεν υπάρχουν μαγικοί τρόποι επιβίωσης σε μια καταρρέουσα Οικονομία. Η Πολιτεία πρέπει, επιτέλους, να αναλάβει τις ευθύνες της. Ζητάμε,...